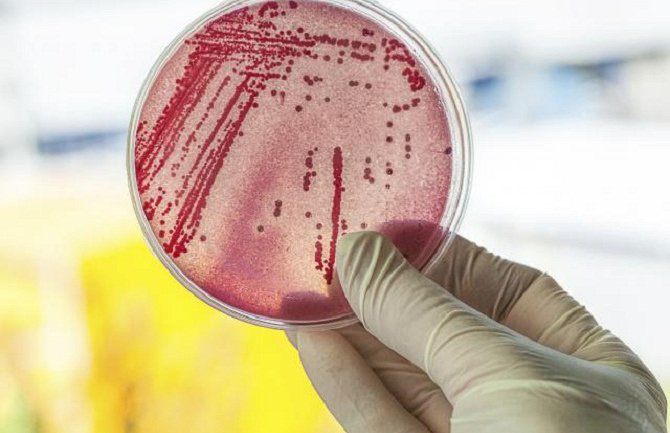
Svijetom se brzo širi bakterija koja razlaže ljudsko tkivo

Bakterije iz grupe streptokoka obično izazivaju bezazlene zdravstvene tegobe poput upale grla i blagih kožnih infekcija, što su zdravstveni problemi koji se lako liječe antibioticima, prenosi B92.
U nešto težim slučajevima bakterija prodie dublje u organizam, uzrokujući upalu pluća, infekcije krvi i nekrotizirajući fasciitis, oboljenje koje karakteriše razlaganje ljudskog tkiva i koje neće preživjeti 25 odsto oboljelih osoba.
Naučnici Kraljevskog koledža u Londonu nedavno su, međutim, otkrili novi podtip bakterije iz grupe streptokoka koja izaziva nekrotizirajući fasciitis.
Nazvana emm89, ova vrsta organizma uzrok je sve većeg porasta infekcije u posljednje vrijeme. Ona proizvodi više toksina i ne posjeduje spoljašnju kapsulu zbog čega se mnogo brže širi i što je čini još invanzivnijom u ljudskom tijelu.
Naučnici navode da nema razloga za paniku jer emm89 još uvijek osjetljiv na penicilin i njemu slične antibiotike. Oni se nadaju da će zahvaljujući dodatnim istraživanjima uspjeti da razviju bolje tretmane za suzbijanje ove bakterije.
Novootkrivena vrsta bakterije
Svijetom se brzo širi bakterija koja razlaže ljudsko tkivo
Novootkrivena vrsta bakterije uzrok je sve brojnijih infekcija u Velikoj Britaniji, Kanadi, Japanu, Francuskoj i Švedskoj.
17. 07. 2015 - 20:11
Komentari objavljeni na portalu Kodex.me ne odražavaju stav uredništva, kao ni korisnika portala. Stavovi objavljeni u tekstovima pojedinih autora takođe nisu nužno ni stavovi redakcije, tako da ne snosimo odgovornost za štetu nastalu drugom korisniku ili trećoj osobi zbog kršenja ovih Uslova i pravila komentarisanja.
Zabranjeni su: govor mržnje, uvrede na nacionalnoj, rasnoj ili polnoj osnovi i psovke, direktne prijetnje drugim korisnicima, autorima čanka i/ili članovima redakcije, postavljanje sadržaja i linkova pornografskog, uvredljivog sadržaja, oglašavanje i postavljanje linkova čija svrha nije davanje dodatanih informacija vezanih za članak.
Takvi komentari će biti izbrisani čim budu primijećeni.





































Komentari